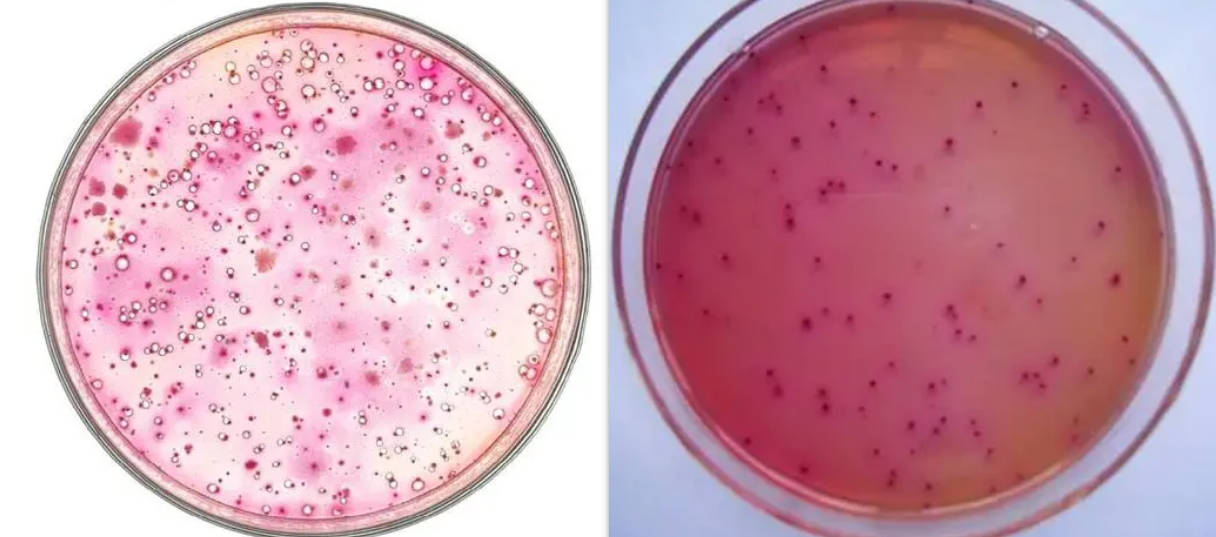

檢測(cè)項(xiàng)目(部分)
菌落總數(shù)、大腸菌群計(jì)數(shù)、大腸桿菌計(jì)數(shù)等
- 菌落總計(jì)數(shù):描述一定量樣本中的大腸菌群數(shù)量,是評(píng)價(jià)環(huán)境衛(wèi)生和食品安全的重要指標(biāo)
- 大腸桿菌:大腸菌群的主要成員,檢測(cè)其存在可以對(duì)環(huán)境衛(wèi)生和食品安全進(jìn)行評(píng)估
- 沙門(mén)氏菌:測(cè)定樣本中是否存在有害的沙門(mén)氏菌,影響食品質(zhì)量和公共健康
- 致病性大腸桿菌:測(cè)定樣本中有沒(méi)有可能引起疾病的大腸桿菌變種
- 源頭判定:通過(guò)分析大腸菌群來(lái)源,幫助找出污染源
- 耐藥性測(cè)定:測(cè)定大腸菌群對(duì)抗生素的耐受程度,有助于合理用藥
- 生物型判別:通過(guò)生物化驗(yàn)和分子生物學(xué)方法對(duì)大腸桿菌進(jìn)行分型,有助于疾病溯源
- 抗原性測(cè)定:測(cè)定大腸菌群的抗原性質(zhì),可為疫苗研發(fā)和疾病防治提供依據(jù)
- 毒素測(cè)定:確認(rèn)大腸菌群是否產(chǎn)生毒素和毒素的類(lèi)型,關(guān)乎食品安全和公共衛(wèi)生
- 運(yùn)動(dòng)性測(cè)定:了解大腸菌群的活動(dòng)能力,可為研發(fā)抑菌產(chǎn)品提供參考
- 大腸菌群總數(shù):測(cè)定樣品中大腸菌群的總數(shù),用于評(píng)估水質(zhì)或食品的衛(wèi)生狀況。
- 大腸桿菌:檢測(cè)樣品中是否存在大腸桿菌,作為糞便污染的指示。
- 腸球菌:檢測(cè)樣品中是否存在腸球菌,也是一種常見(jiàn)的腸道細(xì)菌。
- 菌落總數(shù):測(cè)定樣品中細(xì)菌總數(shù),包括大腸菌群在內(nèi)。
- 腸道致病菌:檢測(cè)樣品中是否存在腸道致病菌,如沙門(mén)氏菌、志賀氏菌等。
- 糞鏈球菌:檢測(cè)樣品中是否存在糞鏈球菌,常見(jiàn)于糞便中。
- 腸道菌群平衡:評(píng)估腸道菌群的平衡狀態(tài),可用于腸道健康的評(píng)估。
- 埃希氏菌:檢測(cè)樣品中是否存在埃希氏菌,常見(jiàn)于腸道和食品中。
- 腸道菌群多樣性:評(píng)估腸道菌群的多樣性水平,反映菌群的復(fù)雜度。
- 糞便致病菌:檢測(cè)樣品中是否存在糞便致病菌,如霍亂弧菌、副溶血弧菌等。
檢測(cè)樣品(部分)
大腸埃希氏菌、檸檬酸桿菌、產(chǎn)氣克雷伯氏菌和陰溝腸桿菌、韻埃希氏菌屬、檸檬酸桿菌屬、魔雷伯氏菌屬和腸桿菌屬等。
- 飲用水大腸菌群檢測(cè)
- 食品大腸菌群檢測(cè)
- 生活飲用水大腸菌群檢測(cè)
- 生態(tài)環(huán)境大腸菌群檢測(cè)
- 醫(yī)院環(huán)境大腸菌群檢測(cè)
- 污水大腸菌群檢測(cè)
- 河流大腸菌群檢測(cè)
- 海洋水質(zhì)大腸菌群檢測(cè)
- 水質(zhì)檢測(cè)
- 食品安全檢測(cè)
- 環(huán)境衛(wèi)生檢測(cè)
- 醫(yī)療衛(wèi)生檢測(cè)
- 動(dòng)物糞便檢測(cè)
- 人體糞便檢測(cè)
- 農(nóng)產(chǎn)品檢測(cè)
- 飲用水檢測(cè)
- 游泳池水檢測(cè)
- 食品加工環(huán)境檢測(cè)
檢測(cè)儀器(部分)
- 實(shí)時(shí)熒光定量PCR儀
- 微生物培養(yǎng)箱
- 高速離心機(jī)
- 顯微鏡
- 細(xì)菌培養(yǎng)基
- PCR試劑盒
- 電子天平
- 生物安全柜
- 脈沖場(chǎng)凝膠電泳儀
- 熒光顯微鏡

檢測(cè)方法(部分)
- 傳統(tǒng)培養(yǎng)法:將樣品接種在適當(dāng)?shù)呐囵B(yǎng)基上,培養(yǎng)并計(jì)數(shù)菌落形成的方法。
- PCR法:利用聚合酶鏈?zhǔn)椒磻?yīng)技術(shù)檢測(cè)靶標(biāo)DNA序列,快速準(zhǔn)確。
- 熒光定量PCR法:結(jié)合PCR和熒光探針技術(shù),定量檢測(cè)目標(biāo)DNA的方法。
- 蛋白質(zhì)芯片技術(shù):利用芯片上固定的蛋白質(zhì)相互作用進(jìn)行檢測(cè)和分析。
- 流式細(xì)胞術(shù):通過(guò)細(xì)胞懸浮液在流式細(xì)胞儀中流動(dòng),檢測(cè)和分析細(xì)胞的特性。
- 質(zhì)譜法:利用質(zhì)譜儀對(duì)樣品中的化合物進(jìn)行分析和鑒定。
- 免疫學(xué)方法:利用抗體與抗原的特異性結(jié)合進(jìn)行檢測(cè)和分析。
- 電化學(xué)法:利用電化學(xué)傳感器檢測(cè)樣品中的化學(xué)物質(zhì)。
- 核酸雜交法:利用互補(bǔ)的核酸序列進(jìn)行雜交反應(yīng),檢測(cè)目標(biāo)核酸的方法。
- 質(zhì)控方法:通過(guò)引入標(biāo)準(zhǔn)品和質(zhì)控樣品,確保檢測(cè)結(jié)果的準(zhǔn)確性和可靠性。
檢測(cè)標(biāo)準(zhǔn)(部分)
DB37/T 3787-2019水質(zhì) 糞大腸菌群測(cè)定 光度法
GB 4789.3-2016食品安全國(guó)家標(biāo)準(zhǔn) 食品微生物學(xué)檢驗(yàn) 大腸菌群計(jì)數(shù)
GB/T 4789.32-2002食品衛(wèi)生微生物學(xué)檢驗(yàn) 大腸菌群的快速檢測(cè)
GB 4789.39-2013食品安全國(guó)家標(biāo)準(zhǔn) 食品微生物學(xué)檢驗(yàn) 糞大腸菌群計(jì)數(shù)
GB/T 5750.12-2006生活飲用水標(biāo)準(zhǔn)檢驗(yàn)方法 微生物指標(biāo)
GB/T 7918.3-1987化妝品微生物標(biāo)準(zhǔn)檢驗(yàn)方法 糞大腸菌群
GB/T 18204.4-2013公共場(chǎng)所衛(wèi)生檢驗(yàn)方法 第4部分:公共用品用具微生物
GB/T 18204.10-2000游泳池微生物檢驗(yàn)方法 大腸菌群測(cè)定
GB/T 18869-2019飼料中大腸菌群的測(cè)定
GB/T 19524.1-2004肥料中糞大腸菌群的測(cè)定
結(jié)語(yǔ)
以上是關(guān)于大腸菌群檢測(cè)的介紹,如有其它問(wèn)題請(qǐng) 聯(lián)系在線工程師 。








第三方檢測(cè)機(jī)構(gòu)



備案號(hào):